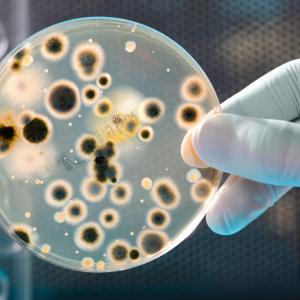

Жените хирурзи спасяват жени-пациентки
Статистиката показва, че от онези жени, които са преживели инфаркт, тези, които са били оперирани от жени-хирурзи в операционната зала, имат по-висок процент оцеляемост. Данните са изведени след проучването на около 582 000 случаи. Отделно, жените имат по-висок шанс да оцелеят в такива случаи, ако мъжете-хирурзи, които ги оперират, се намират в компанията на колеги жени в операционната зала. “Ние бяхме наистина учудени - всеки знае, че високото ниво на обучение и таланта при изключително трудната професия на хирурга са важните фактори за успеха на операциите и въпреки всичко съвпадението между половете на пациентите и хирурзите играе важна статистическа роля”, коментира Сет Карнахан, доцент по стратегия от университета Вашингтон в Сейнт Луис.
“Между личностните отношения, дали са между между мениджър и служител или хирург и пациент създават сърцевината на една организирана система”, добавя той.